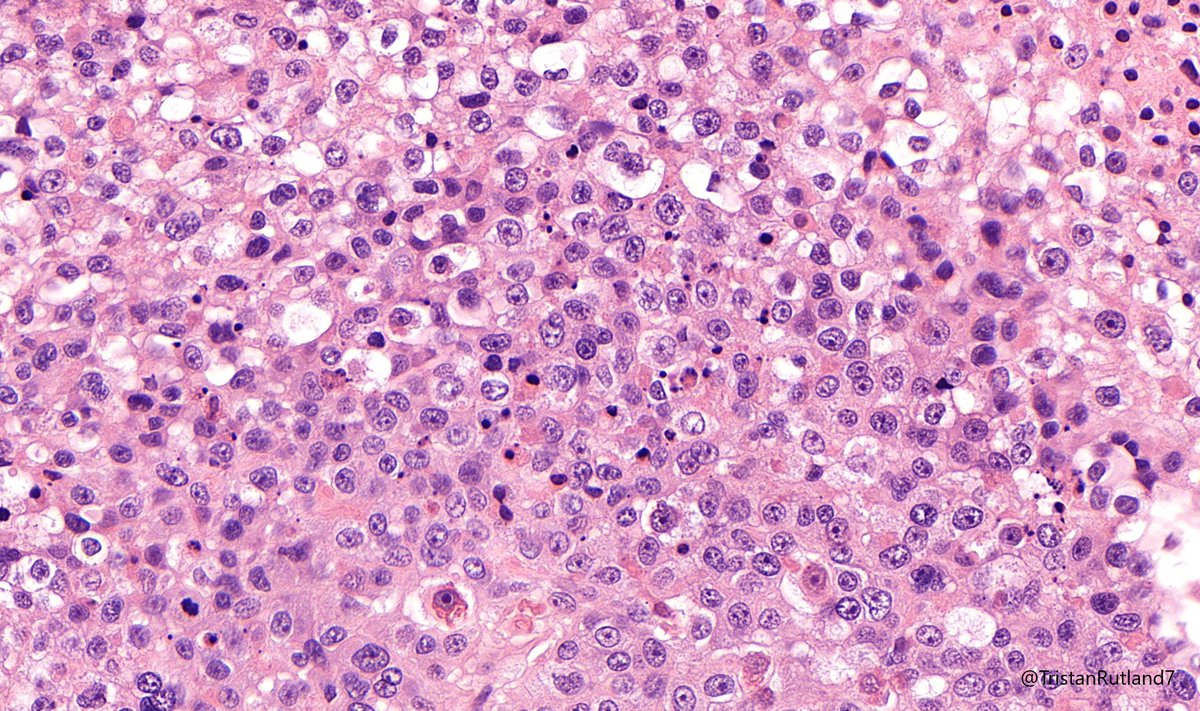
Adult female, reproductive age, omentum.

#BSTpath #Gynpath #GIpath #Pathtwitter #Pathresidents

Paul Drury
@skinpathology
Biomed scientist interest in #dermpath/#skin research/education + #pathology #bstpath #pedipath #hemepath #gynpath #gupath #gipath #breastpath #pathboards
ID: 244445953
29-01-2011 09:48:25
9,9K Tweet
5,5K Takipçi
5,5K Takip Edilen

Daily Mundane for a #dermpath lover😊😂 Jacob Smalberger, M.D. Jonathan He Olaleke Folaranmi Lorand Kis Pepe Jiménez Heffernan @ArjunRamaiya1 Hansini Laharwani Tristan Rutland MBBS FRCPA IFCAP


This was a curbside consult from #dermpath. Patient has a history of mastectomy for breast cancer and is now presenting with a chest wall skin nodule. What is your diagnosis? - IHC: p63 @wusm_pathology WashU Medicine Pathology & Immunology Education #breastpath #PathTwitter #PathX







65 year old man posterior auricular neck deep dermal nodule. easy peezy?#dermpath #PathTwitter #dermatology Etan Marks, DO @ArjunRamaiya1 Lorand Kis Olaleke Folaranmi Tristan Rutland MBBS FRCPA IFCAP Trish Stratus Marcelasaeblima. Allison Osmond MD MSc FRCPC Ahmed Alomari, MD Gonzalo De Toro





Happy Monday everyone! This is an incidental finding in a reduction mammoplasty. What is your diagnosis? #breastpath #PathTwitter WashU Medicine Pathology & Immunology WashU Medicine Pathology & Immunology Education